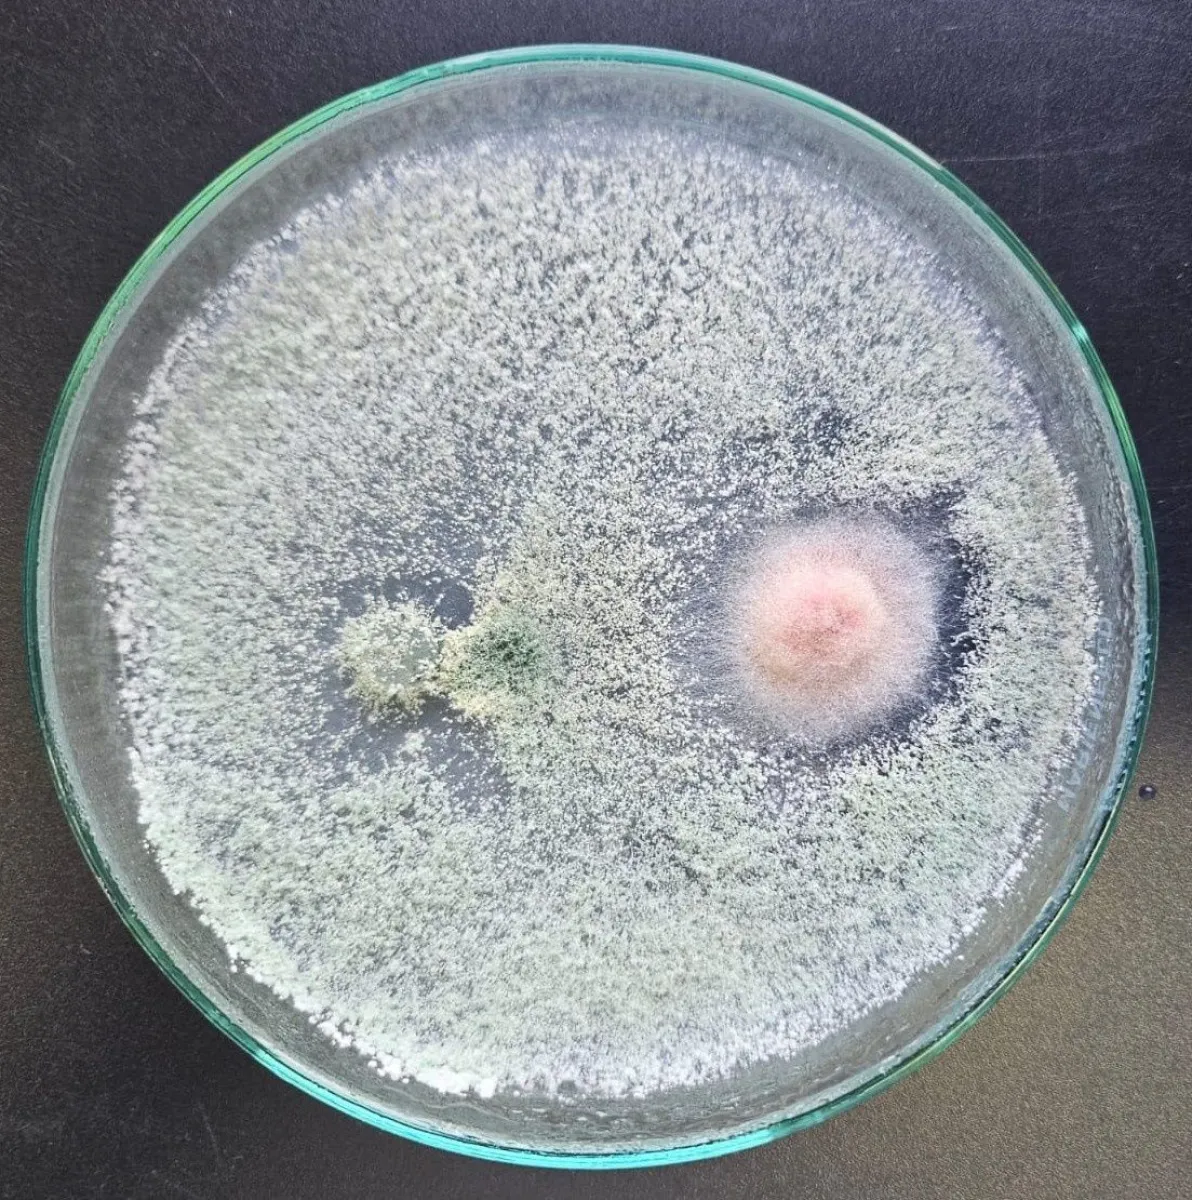

INNOVACIÓN
Científica bolivarense fue premiada por desarrollar un bioinsumo clave para la agricultura en Tierra del Fuego
En el marco de la 5° edición del Programa Tierra del Fuego Innova, se celebró un nuevo avance en materia de investigación vinculado a la producción agrícola sostenible y soberana. El proyecto Tricho DF se quedó con el primer lugar en la categoría Despegue Emprendedor a partir de una investigación encabezada por la bolivarense Paulina Moya junto a su pareja Cristian Carrión.
Tricho DF es un bioinsumo agroecológico formulado a partir de cepas de Tierra del Fuego del hongo Trichoderma spp, tolerantes al frío. Dicho descubrimiento ha demostrado incrementar el 30% de la producción de lechuga en invernáculos y además mejora la salud de las plantas. El proyecto fue desarrollado por investigadores del Instituto de Ciencias Polares, Ambiente y Recursos Naturales (ICPA).
Los impulsores de Tricho DF apuntan a abastecer a productores hortícolas de la provincia de Tierra del Fuego para el próximo año. El proyecto se constituye como el único bioinsumo con potencial uso en cultivos de invierno en la zona centro del país. Además es un avance concreto contra algunas enfermedades que condicionan los cultivos hortícolas de la región.

La ceremonia de premiación se realizó el pasado 6 de agosto en el Campus Ushuaia de la UNTDF. El reconocimiento a Tricho DF abarca un incentivo económico, herramientas de apoyo técnico y un diagnóstico personalizado por parte de la Agencia de Innovación de Tierra del Fuego. Desde La Universidad Nacional de Tierra del Fuego, Antártida e Islas del Atlántico Sur (UNTDF) destacaron la investigación de Moya y Carrión como una alternativa concreta hacia la soberanía alimentaria y capaz de llevar soluciones a la producción hortícola.

Cómo se desarrolló el proyecto y su importancia en Tierra del Fuego, según Paulina Moya
P: - ¿Cuándo decidieron participar del concurso TDF Innova?
PM: - Nos enteramos del concurso gracias a la Secretaría de Desarrollo Productivo y PYME de la provincia de Tierra del Fuego. El Despegue Emprendedor era con emprendimientos que no hayan tenido ventas o que haya pasado menos de dos años que se hayan iniciado en el mercado. Pensamos que era interesante presentarnos para visibilizar el proyecto y porque estamos en la búsqueda de financiamiento en este momento. Nuestra finalidad es generar una biofábrica que produzca bioinsumos para abastecer a los productores de Tierra del Fuego.
El bioinsumo específico que estamos desarrollando es un bioinsumo basado a base de cepas de Trichoderma. Es un hongo que crece en muchos suelos, pero las cepas que estamos utilizando son cepas aisladas de Tierra del Fuego y que están adaptadas a las condiciones de acá. Entonces, nuestra idea es hacerlo crecer, producirlo en un sustrato que sea de origen local, para poder abastecer a los productores de locales en un primer momento. Y posteriormente escalarlo a producirlo para cultivos de clima frío también en el centro del país.
P: - ¿Cuánto tiempo y como se desarrolló el proceso de investigaciones?
PM: - Nosotros comenzamos con nuestras investigaciones en el año 2021, gracias a un proyecto que salió financiado por el entonces Ministerio de Ciencia y Tecnología e Innovación de la Nación dentro del programa Ciencia y Tecnología contra el Hambre. Justamente nosotros presentamos el proyecto que era para desarrollar un bioinsumo con cepas locales del hongo trichoderma y ahí comenzamos. Lo que hicimos fue aislar cepas del hongo de suelos productivos de invernaderos y establecimientos de Río Grande y Ushuaia.
En el laboratorio identificamos y vimos si tenían propiedades para el crecimiento de los cultivos propiedades beneficiosas. Nos quedamos con dos cepas que son las que estamos utilizando actualmente que ya las hemos probado y que son las que tienen propiedades para la promoción del crecimiento vegetal, es decir, que ayudan a las plantas a crecer más y mejor a los cultivos. Por otro lado, también tienen la capacidad de controlar a otros hongos que son patógenos de las plantas. Es muy beneficioso para los cultivos se utiliza como biofertilizante, bioestimulante y como biocontrolador, de enfermedades.

P: - ¿Encontraron dificultades o desafíos considerando el contexto científico argentino?
PM: - Nosotros iniciamos con un proyecto financiado que duró dos años y lo que aprovechamos fue a comprar algo de equipamiento que era lo que necesitábamos para comenzar y cuestiones de instrumentos de laboratorio que se van gastando en el uso. Bueno, pudimos abastecernos dentro de eso que nos duró hasta hace poco y después hemos tenido que buscar financiamiento por otros lugares, no por los lugares convencionales. El sistema científico actualmente es financiado a nivel nacional y todos estamos con muy escaso presupuesto para la ciencia. Entonces hay que buscar financiamiento ya sea en el exterior u asociaciones dependiendo de las temáticas. Pero en este momento sí, hemos tenido que buscar financiamiento por otros lugares para seguir investigando.
El Consejo Federal de Inversiones fue una entidad que, gracias a la Secretaría de Desarrollo Productivo y Pymes de la provincia, nos financió y hasta el momento estamos trabajando con ese financiamiento. Pero a nivel general la verdad que estamos afectados porque muchos de los proyectos que contaban con financiamiento de fuentes como Conicet, Agencia, Universidades, se ven recortados, se ven sin fondos.
P: ¿El proyecto es una apuesta por la soberanía y seguridad alimentaria? ¿porque?
PM: - El proyecto Tricho-DF es una apuesta a la soberanía alimentaria y la seguridad alimentaria de la isla de Tierra del Fuego. En este clima, es muy difícil producir alimentos frescos. La temporada productiva se da desde fines de agosto hasta abril. Entonces el periodo productivo y es muy corto. Hay cultivos que no se pueden hacer por los tiempos de desarrollo del cultivo, por el clima, el frío, las condiciones obviamente no son las óptimas. Entonces cuesta muchísimo producir en la isla. Entonces con este proyecto nosotros lo que queremos es fortalecer o ayudar al sector hortícola fueguino. Justamente con un hongo que crece acá y que tiene propiedades para promover el crecimiento de los cultivos, como proveerles una herramienta más y que sea agroecológica, para que puedan fortalecer los sistemas productivos. Tricho-DF es para fomentar la soberanía alimentaria en el lugar más austral del mundo.
P: - ¿Cuáles son los objetivos a seguir luego de ganar la categoría Despegue Emprendedor?
PM: - Nosotros nos presentamos en este concurso TDF Innova con el objetivo de visibilizar principalmente el proyecto y de contactarnos con otras empresas, con gente que esté también en el ámbito privado porque estamos en esa etapa de escala experimental. Nuestra idea es hacer una biofábrica piloto que pueda abastecer a los productores de Tierra del Fuego. Entonces nos presentamos con esa intención de visibilizar el proyecto y generar lazos con gente interesada, con algunas empresas. El objetivo siguiente es la etapa nacional, esto va a ser en septiembre, compite nuestro proyecto con otros proyectos de otras provincias. Seguimos igual. Nuestro objetivo va a ser visibilizarlo, representar a Tierra del Fuego. Nuestra intención es que nos conozcan, que se interioricen por el proyecto, que nos puedan dar una mano, tal vez alguna empresa interesada que pueda financiar parte de lo que queremos hacer.